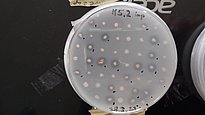
Test von isolierten Bakterien aus der Plastisphäre zum Abbau von Polyurethan, das sich im künstlichen Medium befindet. Bakterien, die eine klare Zone um die Bakterienkolonien bilden, sind in der Lage, Polyurethan abzubauen. Photo: Beat Stierli, (WSL)

Biologische Zersetzung von Plastik bei niedrigen Temperaturen
Anja Werz
Beat Stierli
Ivano Brunner
Joel Rüthi
2020 - 2026
FinancementDie weltweite Plastikverschmutzung ist zu einem dringenden Problem geworden, das die Umwelt und das menschliche Wohlergehen bedroht. Die Zunahme der Produktion und des Verbrauchs von Plastik hat in Verbindung mit unwirksamen Abfallbewirtschaftungsstrategien dazu geführt, dass sich in verschiedenen Ökosystemen wie Ozeanen, Flüssen und Böden erhebliche Mengen an Plastikabfällen angesammelt haben. Selbst sehr abgelegene Regionen in der Arktis und in den Alpen sind mit Mikroplastik verschmutzt. Plastik abbauende Mikroorganismen und ihre Enzyme könnten dazu beitragen, das Plastikrecycling nachhaltiger zu gestalten.
Hintergrund ¶
Die Entdeckung, Kultivierung und biotechnologische Entwicklung von Organismen, die Plastik verdauen können, trägt nicht nur zur Beseitigung der Umweltverschmutzung bei, sondern ist mittlerweile auch ein großes Geschäft. Mehrere Mikroorganismen, die dazu in der Lage sind, wurden bereits gefunden. Wenn jedoch Enzyme, die dies ermöglichen, in industriellem Maßstab eingesetzt werden, funktionieren sie in der Regel nur bei Temperaturen über 30 °C. Aufgrund der erforderlichen Erwärmung ist die industrielle Anwendung bis heute kostspielig und nicht kohlenstoffneutral. Es gibt jedoch eine mögliche Lösung für dieses Problem: die Suche nach spezialisierten, an die Kälte angepassten Mikroorganismen, deren Enzyme bei niedrigeren Temperaturen arbeiten.
Zielsetzung ¶
In diesem Projekt suchen wir in kalten Regionen wie den Alpen oder der Arktis nach solchen Bakterien oder Pilzen, die Plastik abbauen können. Außerdem versuchen wir, die plastikabbauenden Enzyme zu identifizieren und zu charakterisieren, die von den Mikrobenstämmen produziert werden. Die Verwendung des isolierten Enzyms anstelle des Organismus selbst würde es ermöglichen, die Grundbausteine des Plastiks zu gewinnen, die dann zur Herstellung von neuem Plastik verwendet werden könnten. Dieses enorme Potenzial zu erschließen, ist eines unserer Ziele. Wir sind speziell daran interessiert, kälteangepasste plastikabbauende Mikroorganismen zu finden, da ihre Enzyme bei niedrigeren Temperaturen aktiv sind und somit Energie eingespart werden kann.
Aktuelle Entwicklungen ¶
Wir haben eine bemerkenswert große Vielfalt von Mikroorganismen entdeckt, die die Oberfläche von Kunststoffen (die so genannte Plastisphäre) bewohnen, und sie isoliert. Viele dieser Mikroben sind in Bezug auf ihre Lebensweise und ihre Fähigkeiten völlig unbekannt. Wir haben mehrere neue Stämme kälteangepasster, spezialisierter Bakterien und Pilze aus den Alpen und der Arktis identifiziert, die biologisch abbaubare Kunststoffe bei 15°C verdauen können. Darüber hinaus haben wir einige dieser kunststoffabbauenden Enzyme identifiziert, die von den Mikrobenstämmen produziert werden, und sie unter Laborbedingungen zum Abbau von Kunststoffen getestet.
Häufig gestellte Fragen ¶
- Was bedeutet es genau, wenn wir Plastik verdauen, und warum ist das gut für die Natur?
Wenn wir Mikroben für die Plastikverdauung einsetzen, ähnelt der Prozess einem Kompostierungsprozess. Plastik wird in CO2, Wasser und mikrobielle Biomasse umgewandelt. Wenn wir jedoch die isolierten Enzyme der Mikroorganismen verwenden, ist es möglich, die Bausteine des Plastiks zurückzugewinnen, die wiederum zur Herstellung von neuem Plastik verwendet werden könnten. Dies könnte dazu führen, dass weniger Ressourcen für die Herstellung von neuem Plastik benötigt werden. - Was hat uns dazu inspiriert, nach Mikroben zu suchen, die Kunststoff bei niedrigen Temperaturen biologisch abbauen können?
Wir waren daran interessiert, kälteangepasste, plastikabbauende Mikroorganismen zu finden, da ihre Enzyme bei niedrigeren Temperaturen aktiv sind und somit Energie eingespart werden kann. In früheren Studien haben wir beobachtet, dass in den untersuchten Böden aus alpinen und arktischen Regionen eine bemerkenswerte Vielfalt an Mikroorganismen vorhanden ist. Darüber hinaus haben wir festgestellt, dass viele der in diesen Regionen vorkommenden Organismen noch völlig unbekannt sind und wir daher nicht viel über ihre metabolischen Fähigkeiten wissen. Außerdem haben wir festgestellt, dass biologisch abbaubarer Plastik in diesen Böden von einer anderen mikrobiellen Gemeinschaft besiedelt werden als in Böden, die nicht von Plastik betroffen sind. Daraus haben wir die Hypothese abgeleitet, dass biologisch abbaubarer Plastik eine Selektionsdruck auf Mikroorganismen ausübt, Plastik als Energie- und Nährstoffquelle zu nutzen. - Was unterscheidet unsere Arbeit von anderen, die versuchen, die Fähigkeit dieser Organismen zur Beseitigung von Umweltverschmutzung zu nutzen?
Das Neue an unserer Forschung ist, dass die von uns gefundenen Mikroorganismen die getesteten biologisch abbaubaren Kunststoffe bei niedrigeren Temperaturen effizient abbauen können als die meisten bisher bekannten Organismen. Wir hoffen daher, dass wir Enzyme finden können, die bei niedrigeren Temperaturen arbeiten und in Zukunft für enzymatische Recyclinganwendungen eingesetzt werden könnten. - Sind unsere Mikrobenstämme in der Lage, alle Arten von Plastik abzubauen oder nur bestimmte Arten?
Die Mikroben waren nur in der Lage, biologisch abbaubarer Plastik abzubauen. Konventionelles Polyethylen wurde in dem untersuchten Zeitraum nicht abgebaut. - Wie lange würde es dauern, bis diese Mikroben eine erhebliche Menge an Plastik biologisch abbauen können?
Das hängt davon ab, ob der Prozess in größerem Massstab durchgeführt werden kann oder nicht. Derzeit haben wir nur Versuche in kleinem Massstab durchgeführt, bei denen unsere erfolgreichsten Mikroben etwa die Hälfte eines 4 x 4 cm großen Plastikstücks in zwei Monaten abgebaut haben. Wir hoffen auch, dass der Prozess erheblich beschleunigt werden kann, wenn anstelle der Mikroben isolierte Enzyme verwendet werden. Solche Enzyme können in großen Mengen produziert werden. - Wie können unsere Erkenntnisse in praktische Anwendungen für die Abfallwirtschaft und die Recyclingindustrie umgesetzt werden?
Derzeit betreiben wir noch Grundlagenforschung, und es ist zu früh, um Vorhersagen über die Eignung der von uns gefundenen Mikroben für industrielle Anwendungen zu treffen. Das enzymatische Recycling kann jedoch prinzipiell dazu genutzt werden, die Bausteine von Kunststoffen zu gewinnen, die dann zur Herstellung von neuem Plastik verwendet werden können. - Was sind die Grenzen der Studien und was sind die nächsten Schritte?
Die wichtigste Einschränkung ist, dass wir bisher nur den Abbau von biologisch abbaubarem Plastik festgestellt haben. Diese Kunststoffe machen nur einen sehr kleinen Teil aller produzierten Kunststoffe aus. Außerdem haben wir bisher noch keinen vollständigen Abbau eines ganzen Stücks Plastik beobachtet. Es sind weitere Experimente erforderlich, um festzustellen, ob der gesamte Plastik abgebaut werden kann. Der nächste Schritt wird darin bestehen, die plastikabbauenden Enzyme zu identifizieren, die von den Mikrobenstämmen produziert werden. Dann wollen wir mehr über wichtige Eigenschaften wie die optimalen Temperaturen und die Stabilität der Enzyme erfahren und den Prozess optimieren, um große Mengen an Proteinen zu gewinnen. Dies wiederum wird zeigen, ob die neuen Enzyme für einen industriellen Prozess geeignet sind.
Publikationen ¶
Beiträge in den Medien ¶
Blick, Wissenschaftspodcast 'Durchblick', 17.09.2025: Plastikfressender Pilz: Forschung sucht Lösungen
Leister Foundation, 2025: Leister Expedition Go East 2023, Discoveries and Explorations in East Greenland, Artikel von Beat Frey: Macroplastic Litter in Southeast Greenland
Villum Research Station, Station Nord, Aarhus University, Juli 2025: Annual Report 2022-2023, Artikel von Beat Frey & Joel Rüthi: Arctic microbes can degrade bioplastics. Kapitel 5, pp. 20 – 25
Blick, Wissenschaftspodcast 'Durchblick', 18.07.2024: Welche Folgen hat Mikroplastik für Mensch und Umwelt?
SRF Einstein, 09.06.2023: Problem Plastikmüll – Fünf Lösungsansätze für unser Kunstoffproblem
Engelberger Dialoge, 26.10.2023: Mikrobieller Plastikabbau in alpinen Böden
Frontiers Science News, 10.05.2023: Scientists discover microbes in the Alps and Arctic that can digest plastic at low temperatures
BBC News, 11.05.2023: Plastic-eating microbes that work in colder temperatures discovered
WSL Blog, 03.10.2023: Plastikmüll sammeln in unberührten Buchten Südostgrönlands
Elbe-Jeetzel-Zeitung, 05.10.2023: Klimawandel taut uralte Mikroben auf – Mikrobiologe im Interview
Swissinfo, 30.11.2022: Auch biologisch abbaubarer Plastik zersetzt sich nur sehr langsam
WSL News, 30.11.2022: Plastikfresser in alpinen Böden gesucht